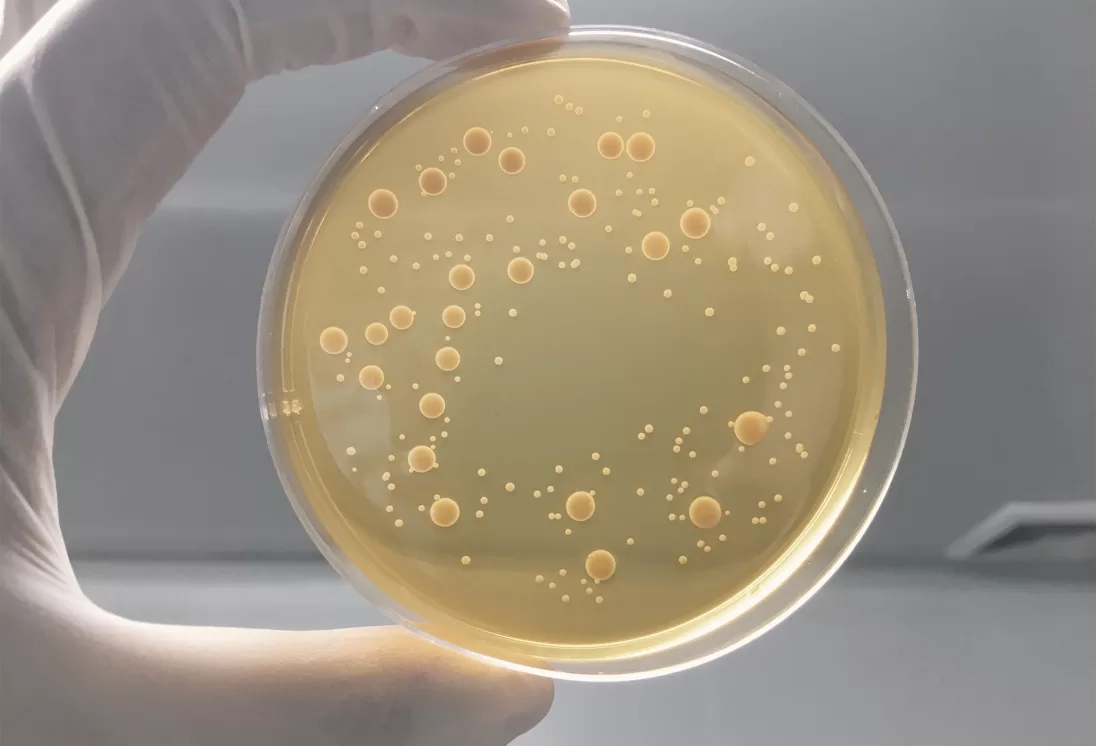

Terragen has a proud commitment to science, research and innovation. Our dedicated team of researchers come from a variety of professional backgrounds including biotechnology, microbiology, plant biology, agronomy, agricultural science and vet science. We also collaborate with research institutions across Australia, giving us access to even more world-class expertise and resources.
Our team continually delivers products based on sound science and takes pride in maintaining focus on relevance to the rural sector. We work with farmers to determine their needs and develop products to meet those needs. Strict product quality standards are maintained throughout the manufacturing process and we are continually improving our research and development as well as our manufacturing practices.
Terragen’s formulations – which aim to reduce the need for antibiotics and chemicals – are set to be game changers in animal health and crop production industries.
Beyond the lab, our research extends to glasshouses, nurseries, field studies and commercial trials – part of our ongoing effort to build knowledge and demonstrate how effective our products are.